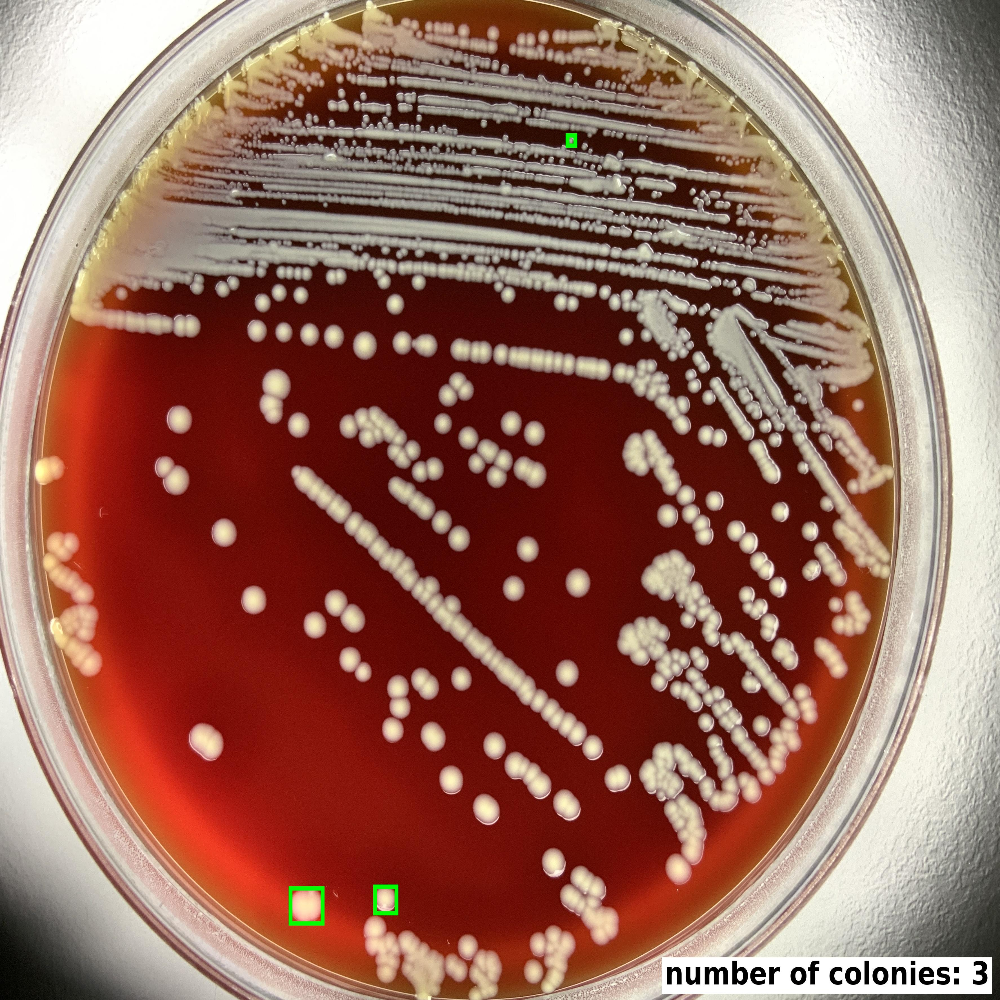
Pick Colony 1.0 - CarbConnect AI-powered medical imaging analysis tool for healthcare professionals and research institutions

CarbConnectfor Organizations
CarbConnectは、病院・大学・研究機関、そして企業の研究開発などにおけるAI画像解析・データ管理・チームコミュニケーションを統合的に運用できるクラウドプラットフォームです。阻止円測定、Nugentスコア評価、血球分類、グラム染色解析などの多様なAIツールに加え、アノテーションやAI開発に必要なラベリングツールも、安全な共有環境と連携機能のもとで効率的に活用できます。

豊富な組織管理機能
CarbConnectは、組織単位でのAI画像解析・データ管理を一元的に制御できるクラウドプラットフォームです。AIモジュールの利用権限、安全な共有、コンプライアンス管理を統合し、画像取得からチームメンバー間のコラボレーションまでをシームレスに運用できます。

組織管理・エンタープライズ監督
チームメンバーの管理、役割設定、アクセス制御を行い、組織全体の利用状況を把握できる包括的な管理パネルを提供します。
- メンバー招待と管理
- 役割・アクセス権限の設定
- 部署単位での構成管理
- 多層的な権限レベル
- 利用状況レポートと監査ログ

AI分析制御・統合
柔軟な統合オプションにより、CarbConnectのAI分析モジュールを組織のワークフローに合わせて管理できます。標準ツールの利用制御に加え、独自AIのカスタム開発や連携にも対応します。
- AIモジュールのアクセス制御
- 分析ワークフローの管理
- 品質管理設定
- カスタムAI開発・統合
- APIを活用した外部連携

リアルタイム コラボレーション・注釈
リアルタイムのチャット・注釈機能で、医療専門家・研究者間の協働を促進。画像上でのマークアップ、同時編集、専門家相談など、距離を超えた連携を実現します。
- リアルタイムメッセージング
- マルチユーザーセッション
- 専門家相談ワークフロー
- インタラクティブな注釈(バウンディングボックス)・ハイライト機能
- リアルタイム ディスカッション スレッド
- マルチユーザー注釈セッション

安全な画像管理
画像を安全に保存・整理・共有できるエンタープライズ水準のセキュリティ環境を提供します。
- エンタープライズレベルのセキュリティプロトコル
- 体系的なフォルダ構造と画像ギャラリー
- 詳細なアクセス権限設定
- HIPAA準拠のデータ管理

ラベリング・AI開発支援ツール
複数メンバーで画像のラベリングを行い、AI学習用データの生成やモデル開発に活用できます。研究・開発現場でのAIトレーニングデータ作成にも最適です。
- 共同ラベリング・レビュー機能
- ML学習用データのエクスポート
- カスタムAI開発サポート
- トレーニングデータセット構築

AI Studio・モデル作成
プロジェクト設定、データセットアップロード、レビュー、学習までを案内するノーコードワークフローで、CarbConnect内に領域特化AIを構築・公開できます。
- S.U.R.T. フロー: Setup, Upload, Review, Train
- 構造化データ・画像・時系列データに対応
- データセットのラベリング・注釈・バージョン管理
- 学習済みモデルをCarbConnectアプリとして公開
ライフサイエンス向けの高度なAIツール
CarbConnectは、医療・バイオテクノロジー・ライフサイエンス分野の研究や開発において、阻止円測定、微生物分析、Nugentスコア評価、骨髄分類、コロニー計数、ラベリング作業、AI Studioワークフロー、獣医応用などに対応する最先端のAIツールを提供します。また、チームコラボレーション機能やカスタムAIモデル開発サービスも統合されており、組織全体でのシームレスなデータ管理と解析を実現します。

ZOI 1.0 - Zone of Inhibition
ペトリ皿上の阻止円を正確に測定し、迅速かつ信頼性の高い細菌增殖分析のための抗菌薬検査を自動化。

Colony Counter
複数の検体タイプで正確で一貫したカウントを行う高度な自動細菌コロニー計数。
Pick Colony 1.0
培養寒天培地画像から優勢な菌コロニー候補を検出し、微生物研究におけるコロニーピッキング作業をより迅速かつ一貫して支援します。

BiTTE lite - Microbial Analysis
7カテゴリーにわたるAI駆動微生物検出:GNR、GNC、GPR、GPC、酵母様真菌、細菌組み合わせ。

Nugent Score AI 1.0
グラム染色显微鏡画像のAI分析を使用し、微生物学者のNugentスコア評価を効率化。

BM Smear AI 1.0
CELLAVISION DC-1イメージングデータセットでトレーニングされたディープラーニング駆動骨髄塗沫分類。

BiTTE® - Microbial Analysis
臨床および研究アプリケーション向けの包括的なAI駆動微生物検出および分類システム。GNR、GNC、GPR、GPC、酵母様真菌、および細菌の組み合わせを高精度で識別します。

ZOI VET - Veterinary Zone of Inhibition
動物ヘルスケアと獣医微生物学アプリケーション向けの獣医特化抗菌薬感受性検査。

ZOI PRO - Professional Zone of Inhibition
ハイスループット検査室環境と要求の高いワークフロー向けの高度自動化を備えたエンタープライズ級阻止円分析。
Labeling Tool – Collaborative Annotation
チームがクラウドプラットフォーム上で直接協力し、バウンディングボックスとコメントで高品質な注釈とラベルを作成。結果は組織内のAIモデル開発にシームレスにエクスポート・適用可能。

AI Studio
実験・研究データを使ってカスタムAIモデルを構築できます。構造化データ、画像、時系列データをアップロードし、学習内容を確認し、結果をテストし、コード不要でCarbConnect内の実用アプリへ展開できます。
CarbConnect for Organizations
病院、バイオテク企業、CRO、大学、研究機関など、あらゆる組織の画像データ管理を変革します。CarbConnectは、安全なチームワークスペース、AI解析機能、ノーコードでモデル開発を進められるAI Studioワークフローを備え、画像の保存・分析・共有を一元的にサポートします。また、情報の分断をなくし、プロジェクトの推進とコンプライアンス強化を実現します。

病院・ヘルスケアネットワーク
病院・ヘルスケアシステム向けのエンタープライズ級医療画像管理。
- 微生物検査室での阻止円検査用AI画像分析
- 部署・専門家間のリアルタイムコミュニケーション
- 外部プロバイダーとの安全な患者データ共有
- グラム染色解釈・細菌同定ワークフロー
- 部門別データセットレビュー、モデル検証、院内解析アプリ公開を支えるAI Studio

大学・研究機関
大学・教育機関向けの学術研究プラットフォーム。
- 血球分類研究用の研究焦点AIモジュール
- 教育目的のための学生アクセス管理
- 多機関プロジェクト用の協力研究ツール
- 婦人科研究アプリケーション用NugentスコアAI
- 研究データセットの版管理、ノーコード実験、学生連携を支えるAI Studio

臨床検査室
臨床診断・検査施設向けの特化ラボ管理。
- 抗菌薬感受性検査用の自動阻止円測定
- 複数拠点ラボネットワーク用クラウドベースプラットフォーム
- 複雑ケースのための専門家相談ワークフロー
- 規制要件のための品質管理・コンプライアンス追跡
- 構造化ラボデータの整理、学習入力のレビュー、業務別モデル最適化を支えるAI Studio

獣医療
動物ヘルスケア向けの特化獣医画像・コラボレーションツール。
- 獣医アプリケーション専用設計のZOI VETモジュール
- 多種細菌同定・分類
- 獣医専門家相談ネットワーク
- ペットオーナーコミュニケーションツール付き診療所管理
- 獣医向けのカスタム解析アプリを学習・検証・公開できるAI Studio

バイオテック研究開発・品質チーム
AI Studio を使って、アッセイ品質管理、顕微鏡レビュー、サンプルトリアージ向けの異常検知・分類モデルを構築できます。
- 異常サンプル、欠陥、ドリフトを検出するノーコード異常検知
- 顕微鏡画像、アッセイ結果、QC ワークフロー向け分類モデル
- 偽陽性をレビューし、チームのフィードバックで再学習し、各データセットを版管理
- CarbConnect 内で QC やトリアージ向けの社内アプリを公開
組織がCarbConnectを選ぶ理由
AI駆動医療画像
阻止円分析、Nugentスコア計算、血球分類、グラム染色解釈に加え、AI Studioによるデータセット準備、ファインチューニング、テスト、社内アプリ化を支える高度なワークフロー。研究用途限定(RUO)に対応。
医療コラボレーション
医療専門家、研究者、専門家間のシームレスなコラボレーションを可能にするリアルタイムコミュニケーションツール。安全な共有機能付き。
クラウドベースプラットフォーム
病院、大学、臨床検査室向けに設計された、エンタープライズセキュリティ、監査記録、スケーラブルなインフラを備えたエンタープライズグレードのクラウドベース医療プラットフォーム。
強力な管理者ダッシュボード
組織のCarbConnectプラットフォームを完全に制御できる包括的な管理者ダッシュボードのプレビューをご覧ください。
CarbConnect

CarbConnect for Organizations – 料金
病院、バイオテク企業、CRO、大学、研究室に合わせて設計された柔軟なプラン。社内コラボレーションや安全な外部共有が必要な場合でも、CarbConnectで画像の管理、コミュニケーション、AI対応データセットの構築が簡単に行えます。
すべてのプランに14日間の無料トライアルが含まれています。続ける準備ができたら、組織のニーズに合わせて、クレジットカード、銀行振込、または電子決済手段(地域によって異なります)から選択してください。

Basic
スモールチーム向けスタータープラン
アプリケーション
主な機能
- ユーザー数: 最大 10
- ストレージ: 最大 1TB
- ラベリングツール: はい
- モデルトレーニングツール: はい
その他:
紹介ストレージボーナスは適用されません

Advanced
成長中の研究室・クリニックに最適
アプリケーション
主な機能
- ユーザー数: 最大 25
- ストレージ: 最大 5TB
- ラベリングツール: はい
- モデルトレーニングツール: はい
その他:
紹介ストレージボーナスは適用されません

Premium
大規模で高度なニーズを持つ組織向け
アプリケーション
主な機能
- ユーザー数: 最大 100
- ストレージ: 最大 15TB
- ラベリングツール: はい
- モデルトレーニングツール: はい
その他:
紹介ストレージボーナスは適用されません
カスタム
エンタープライズ医療組織向けカスタマイズソリューション
アプリケーション
✅ 含まれるアプリ:
- • すべての現在のアプリケーション
- • カスタムAIモジュール
- • ホワイトラベルソリューション
- • オンプレミス展開
- • カスタム統合
- • 専用サポート
- • トレーニング・オンボーディング
主な機能
- ユーザー数: 無制限
- ストレージ: カスタム
- ラベリングツール: はい
- モデルトレーニングツール: はい
受け付け可能な支払い方法
RUOおよびコンプライアンスに関する通知
CarbConnectの一部のAIアプリケーションは研究用途限定(RUO)とされており、追加の検証と規制承認なしでは臨床診断の代わりにはなりません。ワークフローにPHIまたは臨床的決定が関与する場合は、地域の規制要件を確認し、契約書(BAAなど)をリクエストし、セキュリティと暗号化対策を確認してください。詳細はCarbGeM/法務部にお問い合わせください。
ライフサイエンスの現場を、よりスマートに
CarbConnect for Organizationsは、ライフサイエンス領域における画像解析・共有・連携をクラウド上でシームレスに実現する新しいプラットフォームです。研究・臨床・製造など多様な現場で、チームコラボレーションとデータ管理の効率化をサポートします。
CarbConnectを活用し、AI導入をスピーディかつ効率的に
カーブジェンでは、貴社の課題に最適なAIモデルを企画・PoC・実装・運用までワンストップで支援します。 ご相談は無料です。内容に応じて最適な支援プランとお見積もりをご案内いたします。 また、CarbConnectのラベリング機能を活用することで、ユーザーのモデル開発負担を大幅に軽減しながらAI開発を進めることが可能です。 開発したAIモデルは、そのままCarbConnectプラットフォーム上で迅速に実装・運用できます。
ユースケース例
課題整理・導入検討段階の方へ
DXやAIをどのように活用すべきか分からない場合、課題ヒアリングを行い最適な導入計画と開発支援をご提案します。
モデル精度の改善をお求めの方へ
既存モデルの精度が上がらない場合、原因分析を行い、CarbConnectを活用した効率的な再学習・改良をご支援します。
運用設計・実装段階の方へ
開発済みモデルをCarbConnect上で動作するシステムに統合し、現場で使いやすいUI/UX設計とともにスムーズな導入を実現します。
よくある質問
無料トライアルには何が含まれますか?
管理者パネル、AIモジュール、安全な共有機能を含む9つの機能に14日間フルアクセスできます。
いつでもアップグレードまたはダウングレードできますか?
はい、いつでもプランを変更できます。変更は次回の請求サイクルから有効になります。
データは安全に保護されていますか?
もちろんです。医療組織向けのエンタープライズグレードのセキュリティと高度なデータ保護機能を維持しています。
どのような支払い方法を受け付けていますか?
主要なクレジットカード、JCB、デジタルウォレットを受け付けており、エンタープライズ顧客向けに請求書発行も手配できます。